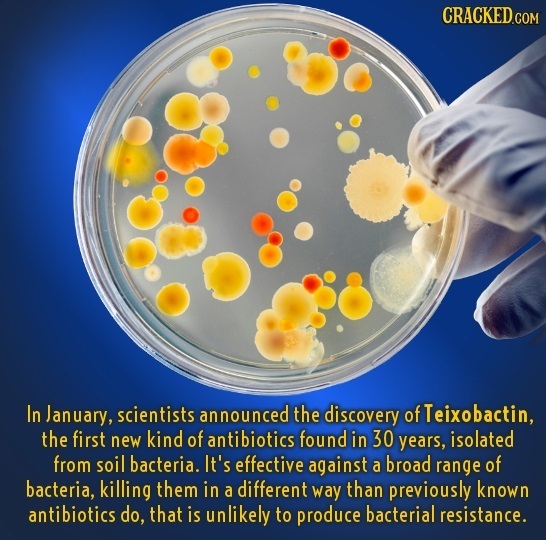
In January, scientists announced the discovery of Teixobactin, the first new kind of antibiotics found in 30 years, isolated from soil bacteria. It's

23 Insane Science Stories The News Forgot To Tell You
Science is awesome. And science news is the kind of stuff we should really be digesting the most of.
You know what's not awesome? All the super dumb or depressing or ridiculous stories the media keeps stuffing into our grey matter. You know what is awesome? Science! And news about what's happening in the scientific community is the kind of stuff we should really be digesting the most of.
To help with this endeavor, we asked our readers to uncover some of the craziest stuff going on that is science-related. We gave cash money for awesome entries, but first the runners-up ...